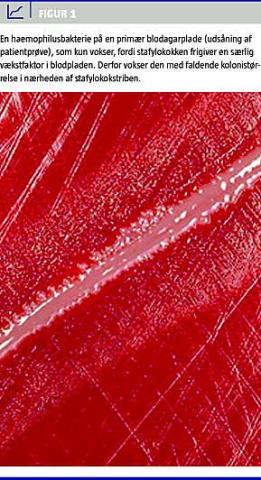

Der beskrives et tilfælde af Haemophilus parainfluenzae- bakteriæmi og meningitis hos en patient med normalt immunsystem.
Bakterien giver sædvanligvis kun anledning til øvre luftvejsinfektioner.
Sygehistorie
En 59-årig kvinde blev indlagt på sygehuset af sin praktiserende læge. Symptomer ved indlæggelsestidspunktet var lænderygsmerter med udstråling til venstresidige gluteal region. Patienten var tidligere rask og modtog ingen daglig medicin.
Symptomerne debuterede tre dage før indlæggelsen med temperaturforhøjelse til 40,1 °C og akut indsættende smerter.
Ved indlæggelsestidspunktet var patienten vågen og klar. Parakliniske resultater viste C-reaktivt protein (CRP) = 3.264 nmol/l (normalt < 75 nmol/l), leukocytter = 5,7 × 109 /l og trombocytter = 20 × 109 /l.
Patienten startede empirisk sepsisbehandling med cefuroxim og gentamicin efter udtagning af bloddyrkninger.
Kort tid efter indlæggelse kompliceredes tilstanden med opkastning og epistaksis. Petekkier udvikledes, og patienten udviklede kramper. På mistanke om meningokokmeningits ændredes den antibiotiske behandling til meningitis-behandling (benzylpenicillin ti mio IE × 2 dagligt), og patienten blev overført til intensiv afdeling. Der blev ikke administreret dexamethason.
Computertomografi (CT) af cerebrum viste ingen patologi, og lumbalpunktur blev udført med udtømning af skyet væske med 832 × 106 /l leucocytter, heraf 599 × 106 /l polymorf-nukleære og 233 × 106 /l mononukleære celler. Proteinindholdet var højt (6,06 g/l) og glukose 3,3mmol/l. Der var ingen bakterier ved direkte mikroskopi.
Bloddyrkningerne viste Haemophilus parainfluenzae (H. parainfluenzae) (fire ud af fire kolber). Patientens behandling ændredes til intravenøst ceftriaxon (4 g × 1 dagligt) i ti dage.
Der var ikke positiv dyrkning fra spinalvæsken, og polymerasekædereaktion (PCR)- undersøgelser for herpes simplex, varicella zoster og enterovirus var negative.
CT-skanningen blev gentaget pga. hallucinationer og paranoia. Undersøgelsen var normal.
Med henblik på påvisning af andre foci blev der udført transtorakal ekkokardiografi, knogleskintigrafi og røntgen af columna uden positive fund.
En ny lumbalpunktur viste faldende leucocytcelletal til 175 × 106 /l, heraf 95 × 106 /l polymorfkernede leukocytter. Protein = 0,47 g/l. Ingen bakterier var set ved direkte mikroskopi.
Magnetisk resonansskanning af cerebrum var udført på mistanke om intracerebral absces. Den var normal.
Der blev undersøgt for komplementfaktordefekt, hvilket ikke blev fundet.
Patienten blev udskrevet uden symptomer 20 dage efter indlæggelsen.
Diskussion
Selv om det ikke var muligt at isolere H. parainfluenzae i cerebrospinalvæsken er det stadig overvejende sandsynligt, at dette er årsagen til meningitis hos denne patient, idet det blev dyrket i fire ud af fire bloddyrkninger. Antibiotika blev ligeledes opstartet før lumbalpunktur, hvilket mindsker chancen for at dyrke mikroorganismen der.
H. parainfluenzae er en gram negativ-ikkekapselbærende bakterie. Identifikationen hviler på fravær af hæmolyse på blodagarplade og behov for faktor V (nicotinamide adenine dinucleotide) (Figur 1 ). Der findes tre biotyper af H. parainfluenzae (A, B, C). Bakterien kan også erkendes ved PCR-teknik.
H. parainfluenzae koloniserer oftest de øvre luftveje og er apatogen der. Den kan også i enkelte tilfælde isoleres fra tyndtarmen og vagina. Normalt giver infektion med H. parainfluenzae anledning til pneumoni, øvre luftvejsinfektion og otitis media.
Komplementsystemet er en vigtig del af det medfødte immunforsvar, og defekter her kan disponere til sepsis og meningitis med bl.a. meningokokker. En sådan defekt (faktor 7) er også beskrevet hos patienter med H. Parainfluenzea -infektion [1].
Enkelte cases af meningitis med H. parainfluenzae uden komplementfaktordefekt er beskrevet, men det har primært været pædiatriske patienter [2], og voksne uden komplementfaktor 7-defekt og med
H. parainfluenzea -meningitis er meget sjældent forekommende [3]. Patienten i denne case var testet for komplementfaktordefekt. Dette blev ikke fundet.
Infektion med H. parainfluenzae er tidligere vist at have en mortalitet på 11% [4]. Det er foreslået, at problemet med at identificere H. parainfluenzae kan være årsagen til den høje mortalitet. I denne case blev den antibiotiske behandling også ændret efter bloddyrkningsfundene, hvilket har givet en kort periode med insufficient behandling.
Der er her præsenteret en case med bakteriæmi og meningitis med H. parainfluenzae hos en voksen patient uden kendt immundefekt og med normalt komplementfaktorsystem.
H. parainfluenzae er ikke tidligere beskrevet som en årsag til meningitis i Danmark. Bakterien må haves in mente som potential årsag til livstruende sygdom, især i patienter med komplementfaktordefekt.
H. parainfluenzae må mistænkes, hvor patienter ikke reagerer på normal meningitisbehandling, og alle patienter med invasiv H. parainfluenzae -infektion bør testes for komplementfaktordefekt.
Ida Kangas , Infektionsmedicinsk Afdeling Q, Århus Universitetshospital, Skejby, DK-8200 Århus N. E-mail: ida@kangas.dk
Antaget: 3. april 2009
Interessekonflikter: Ingen
Taksigelser: Tak til overlæge Alex L. Laursen for konstruktiv kritik.
<ol class="Litt-list">
<li>Drancourt M, Reoult D, Lesavre P et al. Familial deficiency of complement factor 7: association with bacterial meningitis. Apropos of 3 recent cases. Pathol Biol (Paris) 1988;36:825-8.</li>
<li>Watson KC Grimstone J, O'hare AE. Meningitis due to Haemophilus parainfluenzae. J Infect 1981;3:380-4.</li>
<li>Trollfors B, Sandberg T, Brorson JE et al. Invasive infections caused by Haemophilus species other than Haemophilus influenzae. Infection 1985;13:12-14.</li>
<li>Black CT, Grosfeld JL, West KW et al. Haemophilus parainfluenzae infections in children with the report of a unique case. Rev Infect Dis 1988;10:342-6.</li>
</ol>
Summary An adult case of haemophilus parainfluenzae bacterieamia and meningitis Ugeskr Læger 2010;172(1):54-55 A case of bacteriaemia and meningitis caused by Haemophilus parainfluenzae in an adult patient without known immunodeficiency and normal complement system is presented. H. parainfluenzae has not previously been reported as the cause of meningitis in Denmark. Patients with invasive H. parainfluenzea infection should be examined for complement factor 7 defect.